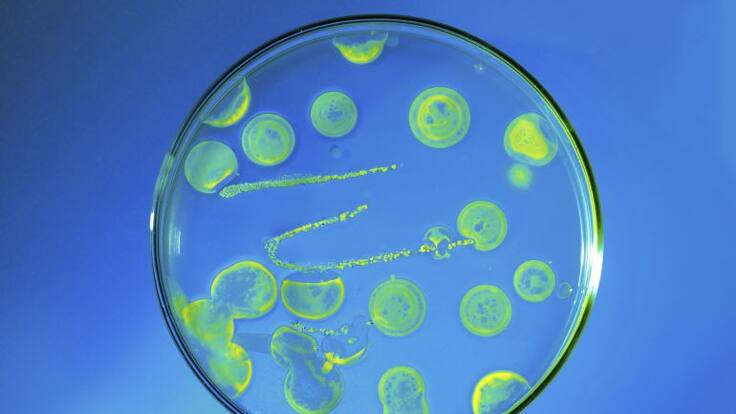
La llavor (26/05/2018)

Virus ‘ensinistrats’
És possible aconseguir que els virus treballen per a nosaltres. Que siga com més prompte millor depén de les administracions
Valencia
Un grup d'investigadors, concretament de Control Biotecnològic de Plagues de la Universitat de València participen en un projecte de recerca europeu, VIROPLANT, destinat a la prop de nous agents virals i a la seua optimització, amb els quals fer front a diferents malalties dels plantes. "Animalets" que poden substituir insecticides.
Mitjançant l’ús de les noves tecnologies de seqüenciació d’ADN i estudis de camp, investiguen productes per al control de plagues que siguen més respectuosos amb el medi ambient.
Salva Herrero, professor del Departament de Genètica, lidera aquest projecte. A ell li preguntàvem en La Llavor si és possible domesticar els virus. I la resposta és domesticar no, però quasi: poden treballar per a nosaltres.
I de cara al futur els insecticides podrien tenir data de caducitat. Però l'arribada d'eixe moment dependrà de les administracions i del que vulguen invertir per a fer realitat del tot alguna cosa que ja comença a aplicar-se a xicoteta escala.

Juan Magraner
Editor 'Hoy por Hoy Matinal Comunitat Valenciana' y director del programa agroalimentario de 'La Llavor'....




